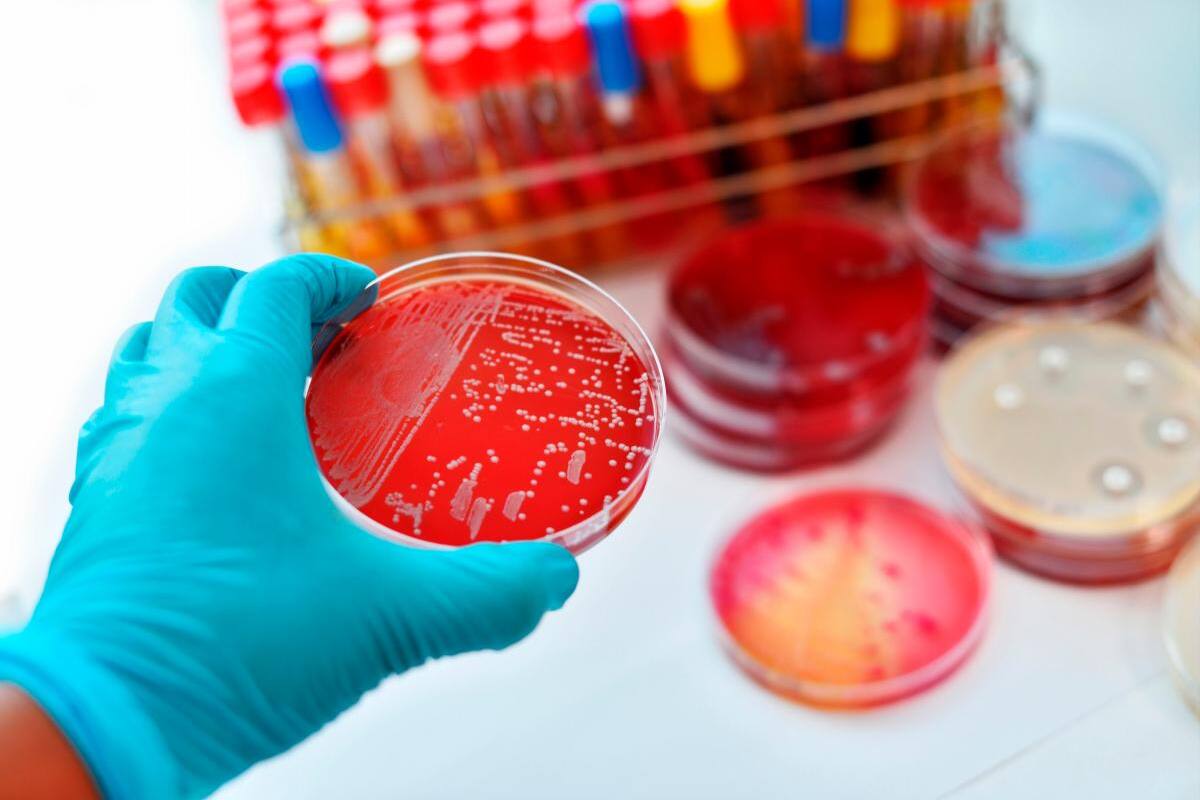
Polémico doctor hacía experimentos con enfermos de alzheimer y párkinson

Las autoridades sanitarias francesas detuvieron un ensayo clínico no autorizado llevado a cabo en unos 350 pacientes, sobre todo enfermos de alzheimer y párkinson, por un polémico doctor que asegura estar inspirado por Dios y que es conocido por su oposición a las vacunas.
La Agencia Nacional de Vigilancia del Medicamento (ANSM, por su siglas en francés) alertó de posibles “riesgos para la salud” entre los pacientes que se sometieron a este tratamiento a base de parches cutáneos en los que los doctores incluyeron una molécula “cuya calidad, efectos y tolerancia no son conocidos”.
El ensayo clínico fue encabezado por el doctor Jean-Bernard Fourtillan, un controvertido médico que, en su página web, asegura que su conocimiento le fue “revelado” como “hombre de fe que ama y escucha a Dios”.
La ANSM le instó a detener el ensayo clínico y a alertar a todos los pacientes, al tiempo que puso el caso en conocimiento de la justicia por esas “prácticas ilegales”, indicó en un comunicado.
También recomendó a los pacientes acudir a su médico de familia y someterse a un chequeo completo para determinar posibles efectos secundarios.
Fourtillan aplicó a los candidatos, enfermos de alzheimer, párkinson y otras patologías neurológicas, parches cutáneos a base de un derivado de la melatonina.
Los responsables procedían a extraer sangre a los pacientes en una abadía cerca de Poitiers, al sur de París, desde la cual eran enviados a un laboratorio, que fue objeto de una inspección de la ANSM, que descubrió así de la existencia del ensayo clínico.
Según la televisión BFM, algunos de los pacientes estaban internos en esa abadía, mientras otros pasaban allí un anoche antes de que se les extrajera la sangre a la mañana siguiente.
La ministra de Sanidad, Agnés Buzyn, calificó de “escándalo absoluto” el “ensayo salvaje” desarrollado “fuera de todo marco ético” y en condiciones “inadmisibles”.
En declaraciones a BFM indicó que los autores de esta práctica ocultaron los pacientes a los médicos y denunció a quienes se aprovechan de la fragilidad de enfermos graves para proponerles “tratamientos milagrosos”.
Buzyn no dio más detalles sobre “la investigación en curso” y aseguró que la prioridad de su departamento pasa ahora por ocuparse de los pacientes afectados.